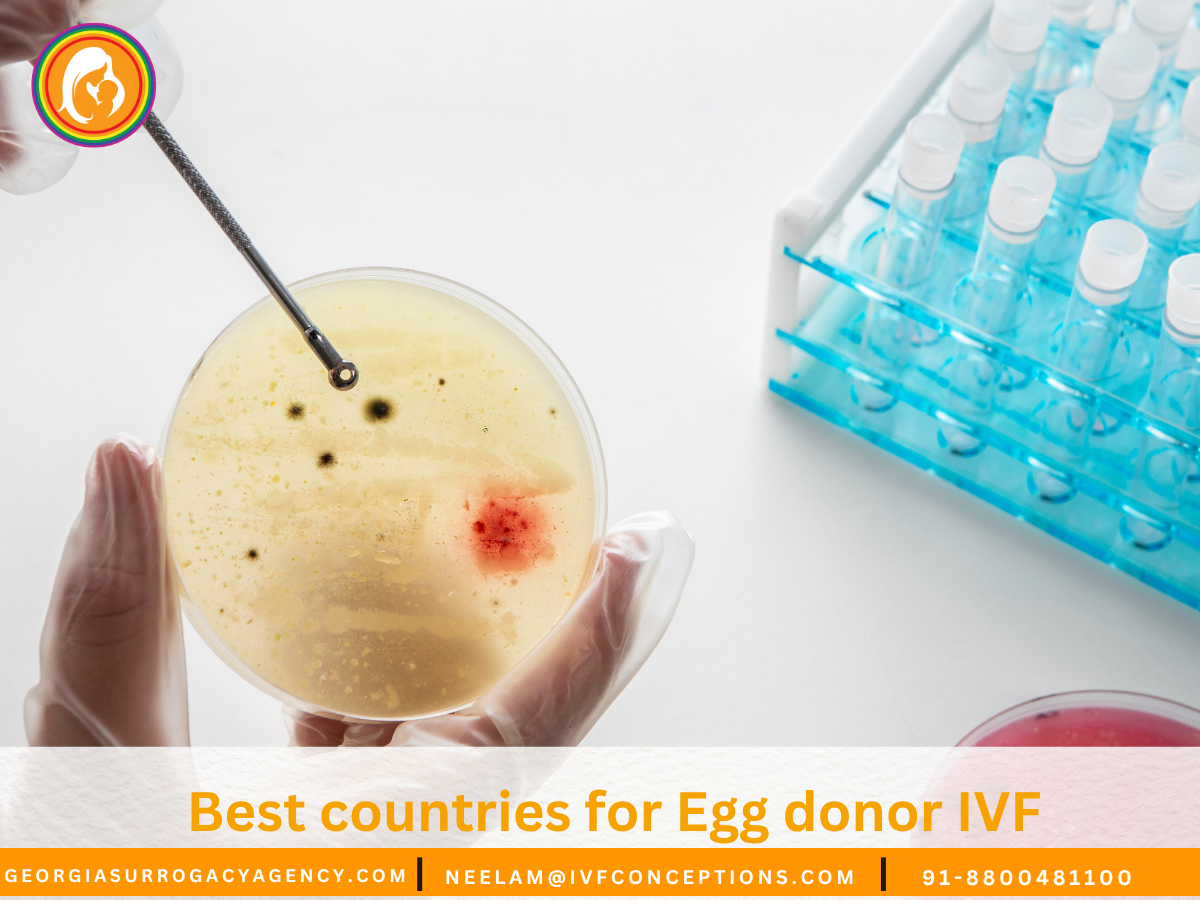
Best countries for Egg donor IVF

Did you know that over 60% of donor egg IVF cycles result in live births, compared to just 30% when using the patient’s eggs? This striking difference drives thousands of hopeful parents annually to explore cross-border fertility treatments, blending advanced medical care with significant cost savings.
Modern fertility clinics worldwide now offer specialized programs combining cutting-edge technology with transparent regulations. For example, the Czech Republic attracts patients with its combination of high success rates, rigorous donor screening, and costs up to 50% lower than U.S. clinics.
This guide examines critical factors like legal frameworks, clinic expertise, and financial considerations. You’ll discover how destinations like Spain and Ukraine balance affordability with quality, while countries like Denmark prioritize donor anonymity and streamlined processes.
We’ll break down practical details – from comparing treatment costs to understanding travel logistics – so you can make informed decisions. Whether you’re navigating age-related infertility or complex medical histories, international options provide new pathways to building families.
Key Takeaways
- Donor egg IVF success rates often double those using personal eggs
- European destinations offer significant cost savings versus U.S. treatments
- Legal frameworks vary widely regarding donor anonymity and compensation
- Top clinics combine advanced technology with English-speaking staff
- Comprehensive packages often include travel coordination services
📞 Get in Touch for a Free Surrogacy Consultation
📱 +91-8800481100 (WhatsApp | LINE | Viber)
📧 neelam@ivfconceptions.com
🌐 www.georgiasurrogacyagency.com
💫 Why Intended Parents Choose Complete Surrogacy for a Safe, Smooth & Successful Surrogacy Journey:
🌍 Access to multiple surrogacy destinations with 15+ years of international experience
🏥 Partnerships with top-tier fertility clinics and agencies, backed by references from past clients
👩🦱 Diverse egg donor options: Asian, Caucasian, African, Oriental, and more
💸 Transparent and affordable pricing—direct payments with no extra agency fees
🔒 No hidden costs—all charges are agreed upon upfront
🤝 Dedicated case manager for personalized support
📲 Fast, honest, and clear communication throughout
📑 Full legal support for visas, documentation, and baby exit processes
🚚 Assistance with frozen sperm/embryo shipment logistics

Introduction to International Egg Donor IVF
When natural conception proves challenging, IVF treatment using donated eggs offers new possibilities. This approach combines eggs from a screened donor with sperm in a lab, followed by embryo transfer to the intended parent or surrogate. Success rates often exceed 60% per cycle, making it a viable path for those facing age-related infertility or genetic concerns.
Understanding the Basics of IVF with Donor Eggs
The process begins with selecting a donor who matches specific health and genetic criteria. Clinics then synchronize the donor’s cycle with the recipient’s using hormone medications. After fertilization, embryos develop for 3-5 days before transfer. Many fertility clinics now use genetic testing to improve implantation success.
Why Explore Treatment Abroad?
Three key factors drive patients to consider cross-border care:
- Cost efficiency: Treatments in countries like the Czech Republic cost 40-60% less than U.S. prices
- Donor availability: Some regions maintain larger databases with diverse ethnic profiles
- Advanced technology: Leading clinics abroad often adopt new techniques faster due to flexible regulations
International options also help bypass lengthy waitlists common in domestic fertility treatments. With proper research, patients access comparable – sometimes superior – medical expertise while managing expenses effectively. Later sections will detail how legal frameworks and clinic standards vary across destinations.
Benefits of Seeking an Egg Donor IVF Abroad
Imagine cutting your fertility treatment costs by half while accessing world-class medical expertise. This reality drives many to explore cross-border egg donation programs, where financial savings meet high success rates. International clinics often provide comprehensive packages covering medical procedures, accommodations, and bilingual coordination services.
Affordable Excellence in Reproductive Care
Patients save 40-65% compared to U.S. prices in destinations like the Czech Republic, where a full donor cycle averages $7,000. These savings don’t compromise quality – European IVF clinics maintain 55-65% success rates through strict embryo screening protocols. “Our international patients receive the same advanced technologies as local clients, just at sustainable prices,” notes a Prague-based fertility coordinator.
Three factors ensure quality:
- Specialists trained at leading global institutions
- ISO-certified laboratory facilities
- Real-time embryo monitoring systems
Expanding Family-Building Possibilities
Global programs offer access to donors matching diverse ethnic backgrounds and physical traits – a crucial advantage for mixed-heritage couples. Spanish clinics maintain donor registries 3-4 times larger than typical U.S. databases, significantly reducing matching times. This variety helps patients find donors sharing key characteristics like educational background or artistic talents.
Streamlined processes benefit time-sensitive cases. Ukrainian centers complete donor matching in 2-4 weeks versus 6+ months domestically. Competitive markets drive clinics to offer personalized attention, with dedicated patient managers handling everything from medication schedules to cultural excursions during treatment stays.
Best countries for Egg donor IVF: A Comparative Analysis
Prospective parents face dramatically different landscapes when evaluating international IVF treatment options. Prices range from €3,000 in Iran to over €12,000 in the UK, with success rates and legal protections varying just as widely. This analysis weighs financial commitments against clinical quality across eight major destinations.
Spain leads in donor diversity with 1,200+ active participants in national databases, while Ukrainian clinics report rapid matching within 14-21 days. The Czech Republic balances cost (€5,500 average) with rigorous embryo screening protocols, achieving 63% live birth rates. “Our patients appreciate having clear legal protections alongside modern lab technologies,” notes a Prague-based fertility coordinator.
Critical differences emerge in regulatory frameworks:
- Anonymous donations: Permitted inthe Czech Republic, Greece, and Russia
- Open-identity systems: Required in Spain and Denmark
- Compensation limits: Ranging from €900 (Spain) to €2,500 (Ukraine)
Iran presents the most budget-friendly egg donation programs at €3,200-€4,100, though some patients report limited English-language support. Conversely, Danish clinics excel in LGBTQ+ inclusivity but carry higher price tags (€8,900+). When selecting destinations, prioritize facilities with ISO-certified labs and transparent success rate reporting – two markers consistently linked to positive outcomes.
Country Spotlight: Czech Republic
Navigating international fertility options reveals standout destinations combining rigorous standards with affordability. The Czech Republic emerges as a leader in reproductive care, blending strict regulatory oversight with IVF treatment costs 40% below Western European averages. This Central European hub attracts global patients through its balance of medical precision and transparent processes.
Regulations, Screening, and Success Rates
Czech law mandates thorough donor evaluations for egg donation programs. Participants must be under 35 and pass 28+ health checks, including:
- Genetic testing for 200+ hereditary conditions
- Infectious disease panels (HIV, hepatitis B/C)
- Psychological assessments
Prague and Brno clinics report 63-67% success rates for donor cycles – among Europe’s highest. “Our triple-layer embryo screening catches 94% of chromosomal abnormalities,” explains a Brno fertility specialist. These protocols help explain why 80% of international patients achieve pregnancy within two cycles.
| Country | Donor Age Limit | Avg. Cost | Success Rate |
|---|---|---|---|
| Czech Republic | 34 | $4,800 | 65% |
| Spain | 35 | $7,200 | 61% |
| Ukraine | 30 | $3,900 | 58% |
Cost Overview and Clinic Reputation
Treatment packages range from $3,000 for basic cycles to $5,500 for programs with genetic testing. Compared to Germany’s $9,800+ fees, Czech IVF clinics deliver equivalent lab technologies at half the price. Top-rated facilities feature:
- ISO-certified embryology labs
- 24/7 patient portals with real-time updates
- Multilingual staff coordinating travel logistics
Over 72% of foreign patients choose Prague-based centers for their combination of historic charm and cutting-edge care. This reputation stems from consistent results – 89% of surveyed couples rated their experience as “exceptionally organized” in 2023 clinic reviews.
Country Spotlight: Spain
Spain’s fertility sector shines with cutting-edge facilities and efficient care models. Over 130 accredited IVF clinics operate nationwide, many equipped with time-lapse embryo incubators and AI-powered selection tools. These advancements contribute to consistent success rates exceeding 60% for donor cycles.
Modern Clinics and Short Waiting Lists
Spanish centers prioritize rapid access – most patients begin egg donation cycles within 4-6 weeks. Barcelona’s Institut Marquès reports 98% of international cases start treatment within 35 days. Clinics streamline processes through:
- Dedicated international patient departments
- Pre-cycle virtual consultations
- Multilingual medical documentation
Pricing Insights and Donor Availability
While Spain’s average $7,500 treatment cost exceeds Ukraine’s $3,900, patients gain access to Europe’s largest donor registry. Over 1,500 active participants enable precise matching for physical traits and educational backgrounds. A Madrid clinic coordinator explains: “Our database updates daily, allowing matches that respect cultural preferences while maintaining strict anonymity rules.”
| Destination | Average Cost | Donor Pool Size | Wait Time |
|---|---|---|---|
| Spain | $7,500 | 1,500+ | 4-6 weeks |
| Czech Republic | $4,800 | 800 | 6-8 weeks |
| Ukraine | $3,900 | 650 | 2-4 weeks |
Higher prices reflect Spain’s mandatory psychological evaluations for donors and extended embryo culture periods. Many clinics include genetic testing in base packages – a cost typically added elsewhere. English-speaking coordinators help navigate these inclusions, ensuring patients understand the value beyond the initial quote.
Country Spotlight: Denmark

Northern Europe’s progressive approach to reproductive care positions Denmark as a trailblazer in inclusive IVF treatment. The country combines ethical rigor with scientific innovation, offering foreign patients streamlined access to high-quality egg donation programs at approximately $5,500 per cycle.
Legal Parameters and Inclusive Policies
Danish law champions equality in reproductive care. Same-sex couples and single women receive the same access to donor programs as heterosexual partners. “Our system recognizes diverse family structures,” states a Copenhagen fertility specialist. “Legal protections ensure equal treatment for all intended parents.”
Donors undergo Europe’s most comprehensive evaluations:
- 25+ medical tests, including chromosomal analysis
- Three-stage psychological assessments
- Mandatory genetic counseling sessions
| Destination | Avg. Cost | Donor Pool | Success Rate |
|---|---|---|---|
| Denmark | $5,500 | 400+ | 62% |
| Czech Republic | $4,800 | 800 | 65% |
| Spain | $7,500 | 1,500+ | 61% |
While donor numbers appear smaller than Spain’s, Danish IVF clinics prioritize quality over quantity. Their focus on advanced embryo selection techniques contributes to consistent success rates above 60%. Patients benefit from:
- AI-powered embryo viability scoring
- Non-invasive prenatal testing options
- Post-treatment genetic counseling
Costs remain competitive despite these innovations. Denmark’s centralized healthcare system allows clinics to maintain strict quality controls while keeping prices 30% lower than U.S. averages. This balance of affordability and expertise makes the country a strategic choice for fertility treatment seekers valuing both medical precision and social inclusivity.
Country Spotlight: Italy
Italy merges centuries of medical tradition with modern fertility treatment innovations. While not always first in donor program availability, the country now attracts patients through regional excellence and evolving inclusivity. Major cities like Rome and Milan host IVF clinics combining Renaissance-era artistry with 21st-century embryology labs.
Healthcare Quality and Regional Differences
Northern centers typically show higher success rates – Bologna reports 63% live births for women under 35 using donor eggs. Southern clinics average 54%, though costs there drop 25%. This regional split reflects:
- Concentration of research hospitals in Milan and Turin
- Varied adoption of preimplantation genetic testing
- Local health authority funding differences
Recent legal shifts now permit egg donation for same-sex couples through court appeals. A Rome fertility lawyer notes: “Judges increasingly recognize international parentage orders, creating new pathways for LGBTQ+ families.”
| City | Avg. Cost | Success Rate |
|---|---|---|
| Milan | $6,200 | 62% |
| Rome | $5,800 | 59% |
| Bologna | $5,500 | 63% |
While pricier than the Czech Republic ($4,800), Italy offers Mediterranean lifestyle benefits during treatment. Many clinics provide cultural orientation programs alongside medical care. Patients gain access to:
- Multilingual genetic counselors
- Historic city center recovery accommodations
- Integrated acupuncture and nutrition services
This blend of clinical expertise and holistic support makes Italy a compelling choice despite moderate price premiums. Ongoing legal reforms suggest broader fertility treatment access could develop in coming years.
According to 2023 clinic reports.
Legal and Regulatory Considerations for IVF Abroad
Understanding legal boundaries becomes crucial when pursuing cross-border reproductive care. Regulations for donor-assisted procedures vary significantly between nations, affecting everything from parental rights to compensation limits. These differences require careful research to avoid unexpected challenges.
Navigating Legal Frameworks and International Laws
Countries approach egg donation with distinct rules. Spain mandates donor-recipient anonymity for 18 years, while the Czech Republic allows anonymous programs. Some regions restrict access based on marital status or sexual orientation.
Key legal variations include:
- Parental recognition laws for same-sex couples
- Compensation caps for donors (€900–€2,500)
- Embryo storage duration limits (1–10 years)
Clinic Accreditation and Rights of Patients
Always verify clinic credentials before committing. Reputable IVF clinics display certifications from organizations like ISO or the European Society of Human Reproduction. These ensure adherence to global medical standards.
Protect your rights by:
- Reviewing treatment contracts with legal counsel
- Confirming embryo ownership clauses
- Requesting data protection policies
| Country | Donor Anonymity | Compensation Limit | LGBTQ+ Access |
|---|---|---|---|
| Spain | No (after 18) | €900 | Full |
| Czech Republic | Yes | €1,200 | Partial |
| Ukraine | Yes | €2,500 | No |
| Denmark | No | €1,000 | Full |
Consulting specialists familiar with international fertility treatment laws helps navigate these complexities. Proper due diligence prevents legal surprises and ensures ethical practices align with personal values.
Factors Impacting IVF Success and Overall Costs
Navigating the financial landscape of donor-assisted procedures requires understanding both medical variables and budget dynamics. Clinic fees often exclude critical components like genetic testing or embryo storage, creating unexpected expenses. Transparent pricing models help patients avoid financial strain while pursuing optimal outcomes.
Treatment Inclusions and Hidden Fees
Base packages typically cover donor compensation and embryo transfers. However, 78% of clinics charge extra for:
- Preimplantation genetic screening ($1,200-$3,500)
- Cryopreservation ($600/year)
- Medications ($1,800-$4,000)
A Prague clinic coordinator advises: “Always request itemized quotes – our patients save 15% on average by comparing line-item charges.” Bundled services in Spain and Denmark often include psychological support, while Ukrainian centers may bill separately for consultations.
| Country | Base Cost | Common Extras | Inclusions |
|---|---|---|---|
| Czech Republic | $4,800 | Genetic testing | Donor screening |
| Spain | $7,500 | Medications | Counselling |
| Ukraine | $5,200 | Embryo storage | Legal support |
Financial Planning for Multiple Cycles
Successful outcomes sometimes require 2-3 attempts. Clinics with 60%+ success rates often recommend budgeting for:
- Additional $2,500-$5,000 per cycle
- Travel expenses for follow-up visits
- Backup donor fees if initial matches fail
Some facilities offer multi-cycle discounts – Spanish clinics provide 10% off subsequent attempts. Payment plans and medical loans help manage costs without compromising care quality. Always verify refund policies for unsuccessful cycles during consultations.
Additional Resources to read:
Best countries for Egg donor IVF
Best IVF Doctors in Delhi, India
IVF and Surrogacy Costs Explained
IVF Terminology and IVF Acronym 101
Conclusion
Exploring cross-border reproductive care opens doors to advanced medical solutions and financial flexibility. Many fertility treatment seekers find international programs offer dual advantages: access to cutting-edge technologies and savings averaging 40-60% compared to domestic options.
Destinations like the Czech Republic stand out for balancing rigorous donor screening with transparent pricing. Others prioritize diverse donor pools or inclusive legal frameworks. What matters most is matching clinic expertise to personal needs – whether prioritizing genetic testing protocols or cultural compatibility.
Those considering egg donation abroad should consult specialists to evaluate both medical and logistical factors. Revisit country-specific details to identify programs aligning with your priorities. With careful planning and expert guidance, international IVF treatment can transform family-building dreams into achievable realities.

FAQs for the Best countries for Egg donor IVF
What factors make a country ideal for egg donor IVF?
Key factors include affordable costs, high success rates, legal clarity, diverse donor pools, and clinic accreditation. Countries like the Czech Republic and Spain excel due to modern facilities, transparent regulations, and experienced specialists.
How do legal frameworks differ between popular IVF destinations?
Laws vary significantly. For example, Denmark allows treatment for single women and same-sex couples, while Italy restricts donor anonymity. Always verify local regulations regarding donor compensation, parental rights, and embryo storage before proceeding.
Are treatment costs lower abroad compared to the U.S.?
Yes. Countries like Ukraine and Iran offer packages 50–70% cheaper than U.S. prices. Spain and the Czech Republic provide mid-range options with inclusive services (medications, screenings) often excluded in base U.S. clinic quotes.
What impacts success rates in international egg donation programs?
Clinic expertise, donor screening rigor, and lab technology play major roles. Czech clinics report 55–65% success rates for women under 35 due to strict donor health criteria and advanced embryo culture techniques.
Can I choose an anonymous or known donor abroad?
It depends on the country. Spain and the Czech Republic enforce donor anonymity, while the U.K. allows identity-release donors when the child turns 18. Clinics in Ukraine often provide detailed donor profiles without identifying information.
What hidden fees should I anticipate during overseas treatment?
Travel, accommodation, and legal consultations add to base costs. Some clinics charge extra for embryo freezing or genetic testing. Ask for itemized pricing upfront—reputable centers in Denmark and Spain typically outline all expenses clearly.
How many treatment cycles might be necessary?
While some achieve pregnancy in one cycle, others require 2–3 attempts. Clinics in Greece and Russia often offer discounted multi-cycle packages. Your age, ovarian reserve, and embryo quality will influence this number.
Are international clinics accredited to global standards?
Top destinations like the Czech Republic and Spain have clinics certified by ISO or the European Society of Human Reproduction (ESHRE). Always verify certifications and read patient reviews to assess quality.

Highly esteemed, authoritative, and trusted professional with a 14-year of experience in international surrogacy. Advocate for Secure, Legal, and Affordable International Surrogacy.
Neelam Chhagani, MA (Counselling Psychology) and Holistic Infertility and Third-Party Reproduction Consultant.
Member of European Fertility Society, Best Surrogacy Blogger of 2020, with 300 dedicated blogs, and top contributor on Quora for Surrogacy.

Add Your Comment